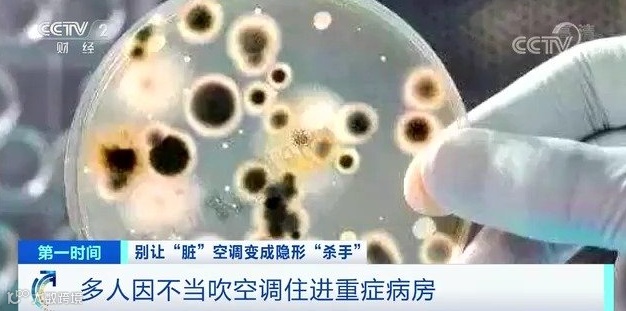

点击蓝字
关注我们
天气越来越热了,嗯,是时候开空调了。
不过,小编还是要建议您在开空调前,先做一件事:洗空调。
这些就是还没拆开清洗过的空调,可能你家正使用着这样的空调,每天生活在这层“恐怖阴影”中。
中国疾病预防控制中心公布的北京地区家用空调卫生状况调查结果显示,家用空调的污染状况极为严重,细菌数量最严重的超标近百倍。
像是霉菌,会侵入人的皮肤系统和呼吸道,而大肠杆菌和金色葡萄球菌则可能引起腹泻等消化系统疾病。
细菌会随着空调的运转,污染室内空气,你要是长期处在这样的环境里,就很容易染上疾病,更别说孩子和老人等免疫力较差人群了。
另外,污垢附着在空调的滤网、散热片等零部件上,也会影响空调的制冷和制热性能。

说到这里,我们再次划重点:空调一定要记得经常清洗!
在每年夏季和冬季第一次用空调前,一定要对它进行一次深度彻底的清洗。
空调为什么会这么脏
空调运行时,室内是一个密闭空间,空气不流通,人体产生的代谢物、废气,生活中产生的的尘埃和颗粒物,都会随着室内空气循环进入空调中,让空调变脏。
空调内最脏的部分主要是两大块,散热片和滤网。
散热片可以说是空调中最脏的地方了。它就像空调的“心肺”,一般在空调过滤网后面,是空气在空调内冷热交换的必经之地。
空气中的灰尘、污垢不断累积在散热片上,再加上空调冷凝水造成的潮湿环境和空调运转时适宜的温度,让它成为了病菌滋生的温床,导致病菌大量繁殖。
滤网是空调上的初级过滤系统,主要是过滤空气中的灰尘。一个滤网长期未清洗的空调,就像一个室内颗粒物污染制造机,只要你打开空调,滤网上的尘埃就会源源不断地输送到你的房间中。
除了这两个藏污纳垢的大户,风轮、扇叶,以及机身的缝隙里,都有可能因为室内空气循环,而藏着很多灰尘和细菌。所以,我们洗空调的重点部位就是这么几个:散热片、滤网、风轮和扇叶。当然,一般也是要洗一洗机身、外壳之类的地方了。
自己洗空调的弊端

自己使用空调消毒剂清洗空调,人与消毒剂会近距离接触,即使戴好口罩和手套,呼吸道和皮肤也难免会碰到少量消毒剂,其次,空调内部有些是不耐腐蚀的金属零件,自己使用空调消毒剂清洗,容易造成空调内部元件损坏,引发空调故障。
有的朋友会通过小广告找一些清洗游击队来清洗空调,不仅服务没有保障,而且会出现乱收费的现象,造成不必要的损失。

因此,建议对空调进行深层清洁时,最好请专业机构服务人员。一方面能避免错误拆卸零件导致空调损坏,另一方面明码标价,无任何隐形消费。
e帮手 您的专属生活管家
我们所熟悉的“空调病”,有极大可能就是因为空调的长期不清洗导致的,细菌在不断滋生,吹出的风又怎么能让人安心!
空调清洗刻不容缓!现在就下单e帮手,专业团队,师傅迅速响应!省时省力又省心!



